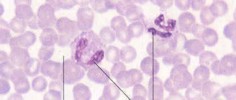

1. Epithelial
2. Connective
3. Muscle
4. Nervous
Epithelial Tissue

There are 3 shapes of epithelial cells: Squamos, Cuboidal, and Columnar.
These cells can be arranged in 3 different ways:
1. Simple = a single layer of cells
2. Stratified = many layers of cells (same shape of cells)
3. Transitional = many layers of cells of differeing shapes





These are the most abundant types of tissue within the human body. Skin, muscles, bones, ligaments, and blood are just a few examples of the different types of connective tissues. This type of tissue is found inside of a matrix or surrounding material. What type of matrix are blood cells found in?
Red blood cells are plentiful. White blood cells and platelets are floating within a liquid matrix of plasma.
Red blood cells are plentiful. White blood cells and platelets are floating within a liquid matrix of plasma.
 Adipose tissue is made up of cells that store lipids (fat) and stick together in a soft, sticky gel-like matrix.
Adipose tissue is made up of cells that store lipids (fat) and stick together in a soft, sticky gel-like matrix.

 Bone and cartilage
Bone and cartilage
There has been a link between shark cartilage and a treatment for cancer. In the presence of cartilage, blood vessels do not grow. Therefore, applying cartilage near tumors will inhibit the growth of blood vessels to the tumor and the tumor cannot grow.
 Smooth muscle = intestines, urinary tract, organs, etc.
Smooth muscle = intestines, urinary tract, organs, etc.
 Cardiac muscle = heart tissue.
Cardiac muscle = heart tissue.
 Skeletal muscle = biceps and other muscles that attach to bone.
Skeletal muscle = biceps and other muscles that attach to bone.
Muscle move your body parts. Most muscles are attached to bones, though not all muscles are. Your bicep is an muscle on your upper arm which is attached to the humerus bone. Your heart is made up of muscle but does not touch any bone.
Muscles contract (move) by electrical impulses which are messages being sent from the brain.
More on Muscles
 Nervous tissue is a webbed network of neurons relaying information within a matrix of glia.
Nervous tissue is a webbed network of neurons relaying information within a matrix of glia.